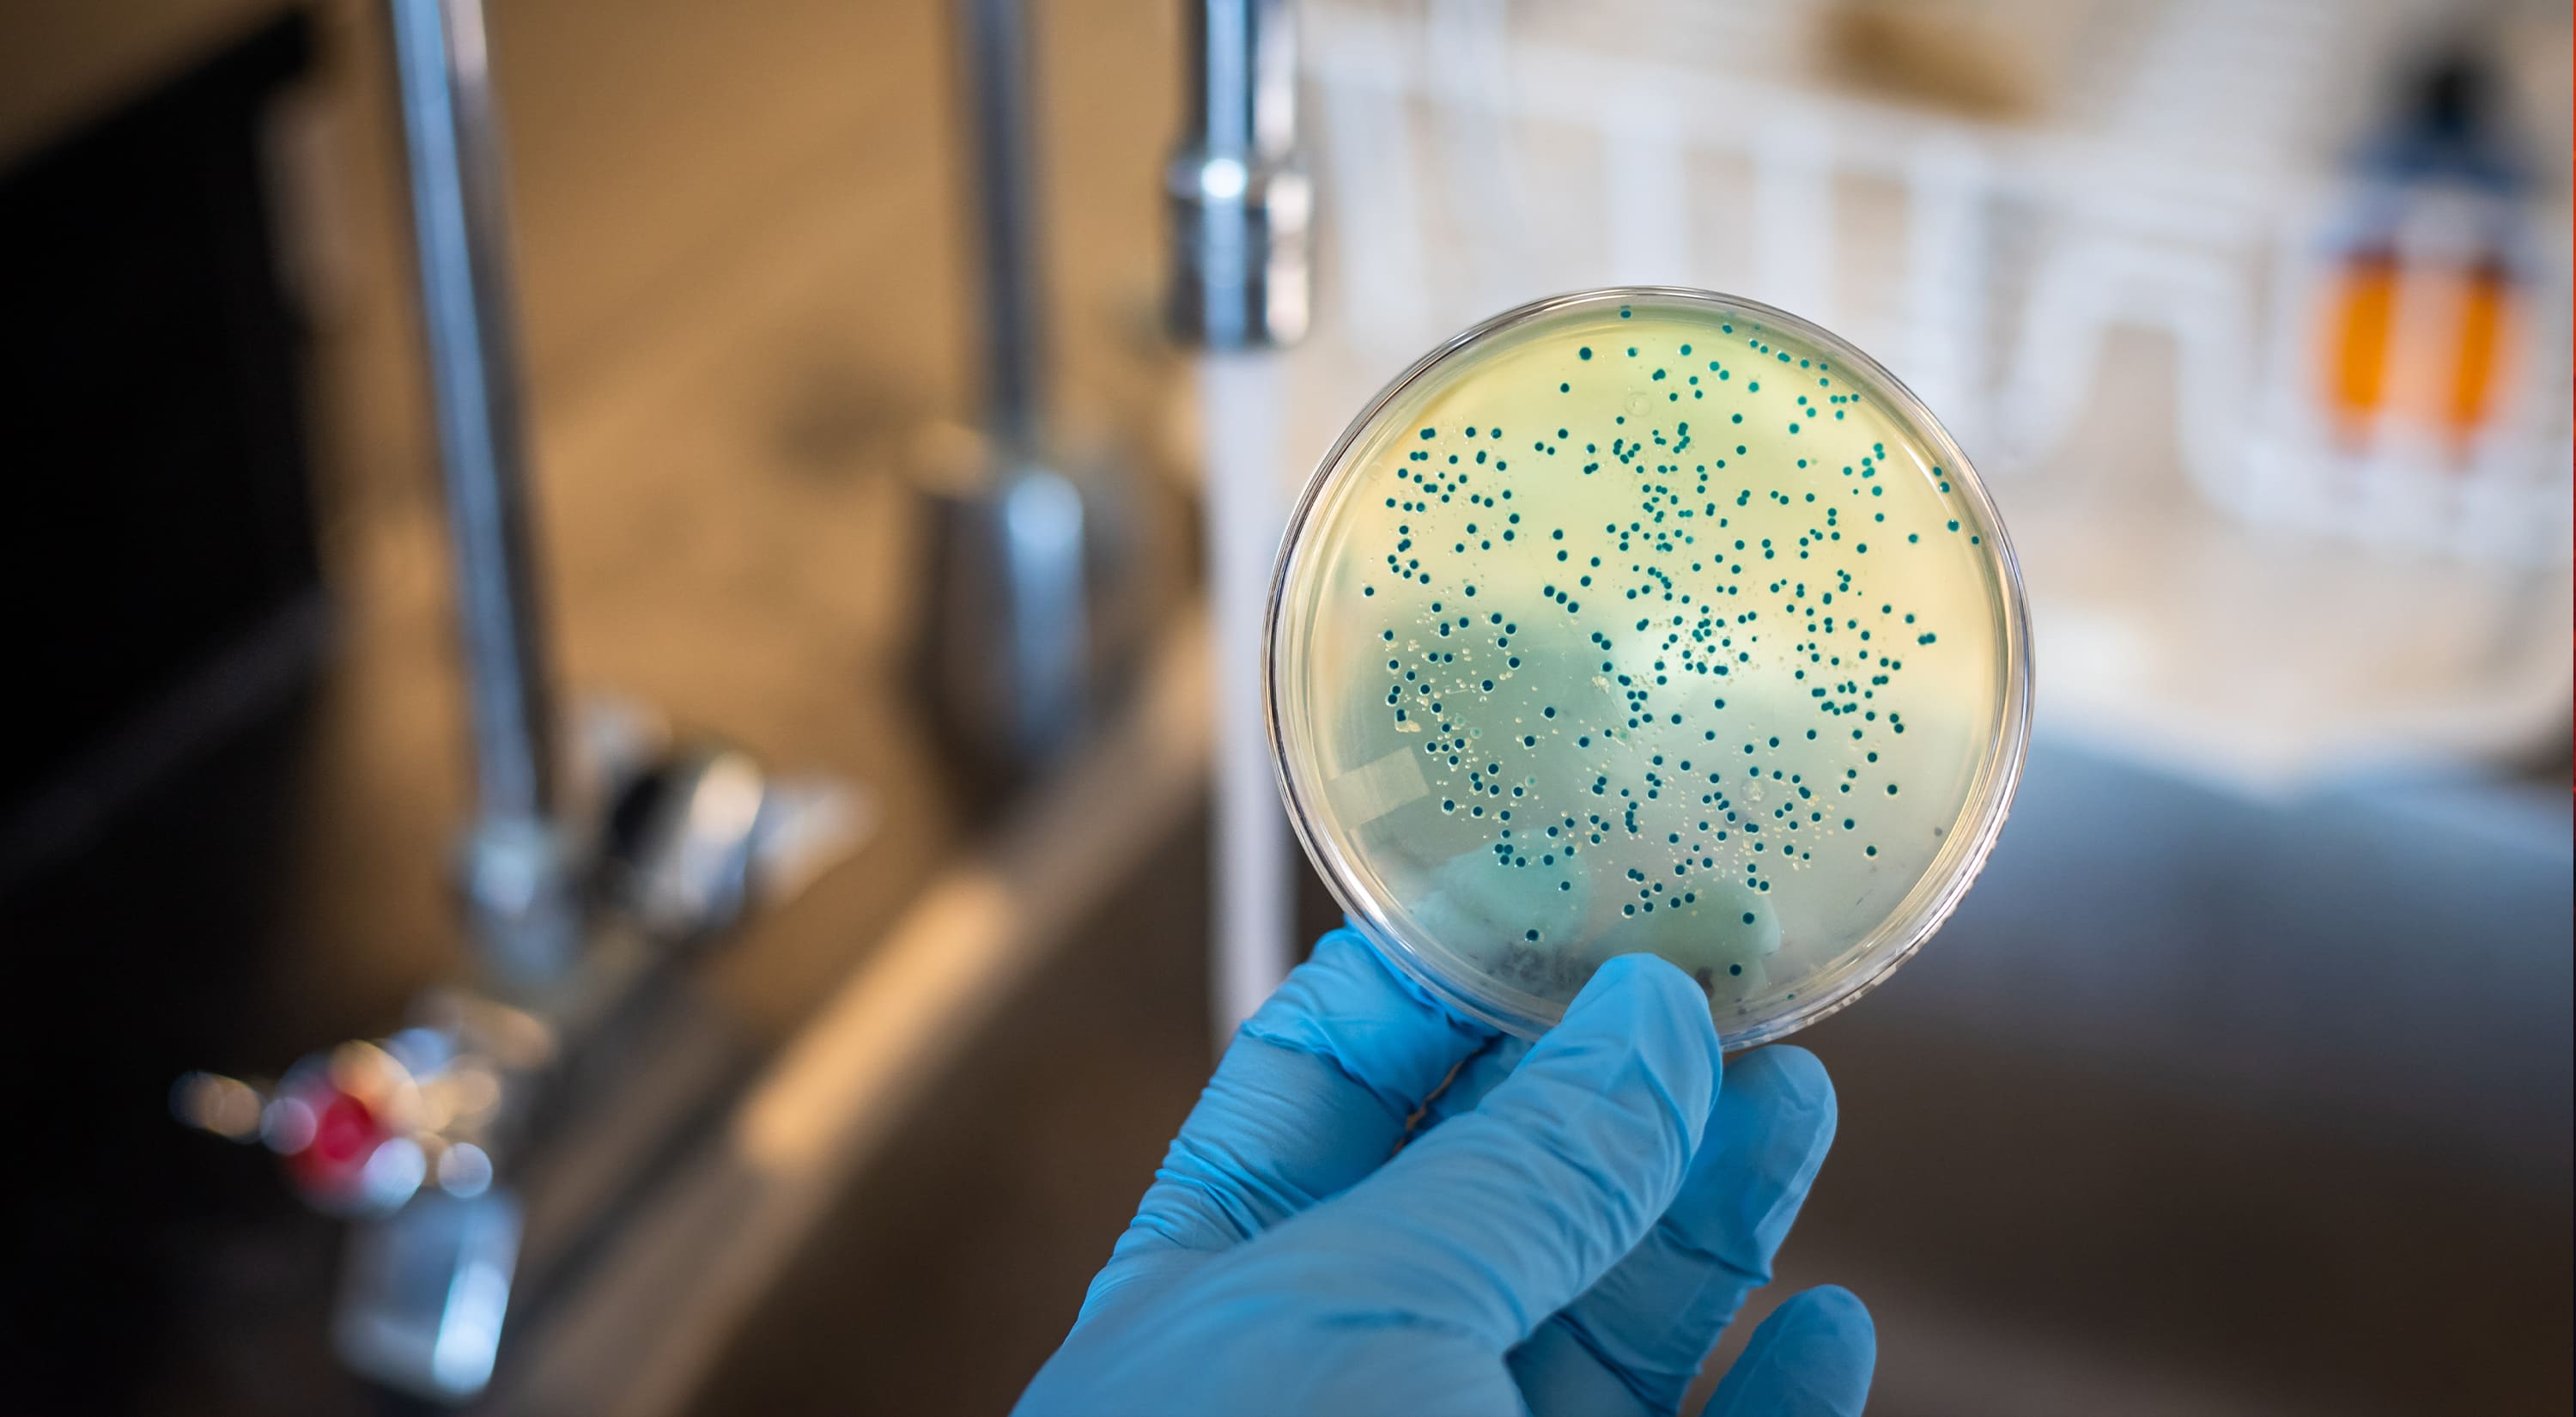
Image

Welcome To
UNIMAS Innovation
RDICE leads UNIMAS’s efforts in research, innovation, and commercialisation through strategic management and partnerships.

The Colourful Journey of UNIMAS Research
Innovative Research & Discovery
Driving UNIMAS’s research and innovation through collaboration and excellence.

The Amorphophallus Plants of Borneo
Insights into their diversity will help to understand and protect them and their natural environment
> Find Out More
> Find Out More

An App for Dengue
MozzHub, a user-friendly dengue hotspot detector, could significantly assist the management and control of dengue.
> Find Out More
> Find Out More

Turning Up the Heat on Composites
Experimental analysis and computer simulations reveal how woven fabric composite materials are deformed by heat.
> Find Out More
> Find Out More
Bacteria Power
Bacteria living on soil and chicken manure could provide low-tech and sustainable green energy
> Find Out More
> Find Out More

Absorbing impact: Inside the head of a Woodpecker
Inspired by the woodpecker’s resilience, Malaysian engineers used simulations to enhance composite beam designs for impact-prone structures.
> Find Out More
> Find Out More

Au naturel approaches for healthcare and biodiesel production
Researchers in Malaysia are using the chemistry of natural products for sustainable health and energy solutions.
> Find Out More
> Find Out More

The evolutionary history of puddle frogs

Vaccines and vitamin D: Measuring immune response
Researchers in Sarawak, Malaysia, measured the immunity responses of people who received different COVID-19 vaccines.
> Find Out More
> Find Out More
Driving Research Excellence Through Innovation
Workshops to empower impactful research, publications, and innovations.
20 May 2026 | 9.00 AM
Pitch, Propose & Present : Essential Consultancy Skills For Academics
Speaker:
- Winnie Wong

6 May 2026 | 2:30 PM
Book Authors Wanted
Speaker:
- Professor Dr. Evan Lau Poh Hock

21 April 2026 | 2:30 PM
Making Every Cent Count....Correctly Managing Your Grant Expenses
Speaker:
- Madam Sharosliza binti Azman

8 April 2026 | 9:00 AM
Leveraging AI for Smarter Research
Speaker:
- Prof. Ir. Dr. Ahmad Kamal Ariffin Mohd Ihsan

26 February 2026 | 9:00 AM
Pastikan Tepat! Pengurusan dan Pelaporan Geran Penyelidikan Anda
Speakers:
- Professor Dr Awang Ahmad Sallehin bin Awang Husaini

9 February 2026 | 9:00 AM
Cradle Fund Financing & Grant Proposal
Speaker:
- Mohd Noor Hisham bin Abdul Bari
- Vinodhnee Seenivasalu

2 February 2026 | 9:00 AM
Bengkel Pemantapan dan Penyediaan MyRA
Speaker:
- Prof Dr Mohammad Hamiruce Marhaban

UNIMAS Research Clusters
UNIMAS organises its research into strategic clusters that reflect the university’s strengths and Sarawak’s unique contexts. These clusters foster interdisciplinary collaboration, address local and global challenges, and drive impactful research and innovation.
Natural sciences have been a foundational pillar of research at UNIMAS since its inception. This cluster emphasizes scientific inquiry and evidence-based exploration, particularly focusing on Sarawak’s rich natural resources. Research spans both basic and applied sciences, employing innovative and multidisciplinary approaches to better understand ecosystems and the vast potential of biodiversity. The University provides a dynamic platform for research across key disciplines such as biology, chemistry, ecology, and biotechnology.
Discover More >>
Discover More >>




